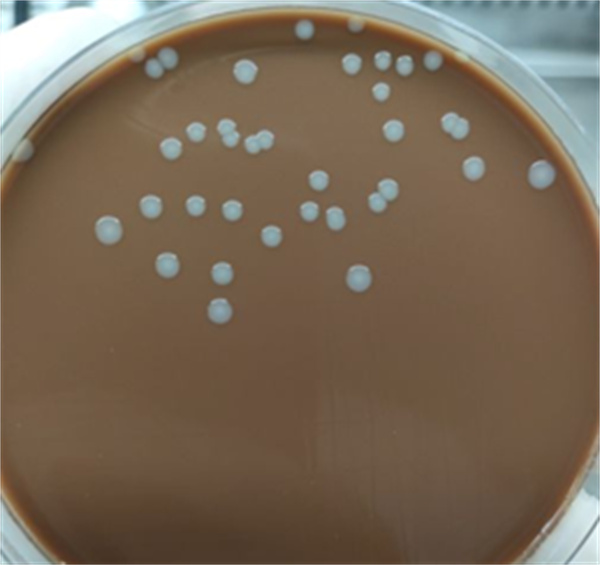

健康科普
健康知识
【睛心检验】细菌、真菌—检验科是如何区分这些“坏家伙”的?
在医学检验领域,细菌和真菌是常见的病原体,它们虽然都可能引发疾病,但两者的结构、生长特性、检测方法以及对治疗的反应都有显著差异。那么检验科如何通区分细菌和真菌,来为临床诊断和治疗提供依据的呢?今天我们就来带大家了解一下检验科的“手段”。
一、细菌与真菌的基本区别
(一)结构差异
1、细菌:细菌是单细胞生物,具有细胞壁、细胞膜、细胞质和核糖体等基本结构。根据细胞壁成分的不同,细菌可以分为革兰氏阳性菌和革兰氏阴性菌。

图1 细菌结构示意图
2、真菌:真菌包括单细胞的酵母菌和多细胞的霉菌。它们具有细胞壁,但细胞壁成分与细菌不同,主要由几丁质构成。

图2 真菌(酵母菌)结构示意图

图3 真菌(青霉菌)结构示意图
(二)生长特性
1、细菌:细菌生长速度快,通常在数小时到数天内形成可见菌落。它们可以在多种培养基上生长,如血平板、巧克力平板等。

图4 细菌在血平板生长状态
图5 细菌在巧克力平板生长状态
2、真菌:真菌生长速度较慢,通常需要数天到数周才能形成明显菌落。真菌培养需要特定的培养基,如沙氏培养基。

图6 真菌在沙氏培养基生长状态
二、检验科的检测方法
(一)显微镜检查
1、细菌:通过革兰氏染色,可以将细菌分为革兰氏阳性菌和阴性菌。革兰氏阳性菌呈紫色,阴性菌呈红色。

图7 革兰氏阳性菌和阴性菌显微镜下示意图
2、真菌:真菌在显微镜下通常呈现不同的形态。例如,念珠菌可见圆形或卵圆形的芽生孢子及假菌丝。

图8 真菌(念珠菌)显微镜下示意图
(二)培养与鉴定
1、细菌培养:将标本接种到合适的培养基上,根据菌落形态、颜色、边缘特征等初步判断细菌种类,再通过生化反应进一步鉴定。
2、真菌培养:真菌培养需要使用特定的培养基,如沙氏培养基。对于一些特殊真菌,可能需要添加特定的营养物质或抑制剂。
(三)分子生物学检测
1、细菌:通过PCR技术扩增细菌的特异性基因片段,如16S rRNA基因,进行序列分析以鉴定细菌种类。
2、真菌:真菌的分子检测通常针对其核糖体DNA的内转录间隔区(ITS)等特异性基因片段进行PCR扩增和测序。
(四)免疫学检测
1、细菌:通过检测细菌抗原或抗体来辅助诊断,如检测肺炎链球菌的抗原。
2、真菌:检测真菌抗原或抗体,如检测念珠菌的甘露聚糖抗原。
三、临床意义与应用
(一)细菌感染
细菌感染通常需要使用抗生素进行治疗。检验科通过检测细菌种类和药敏试验,为临床选择合适的抗生素提供依据。
(二)真菌感染
真菌感染的治疗则较为复杂,需要根据真菌种类和染部位选择合适的抗真菌药物。检验科的检测结果有助于临床制定个性化的治疗方案。
检验科通过多种检测方法,能够准确区分细菌和真菌,为临床诊断和治疗提供重要支持。了解这些检测方法和原理,有助于我们更好地理解检验报告中的结果,从而更好地配合医生进行疾病的治疗和管理。
部分图片源自网络,如有侵权联系删除。
检验科简介

检验科是一旨在为诊断、预防、治疗人体疾病或评价人体健康提供信息的综合性、现代化临床医学实验科室。拥有临检、生化、免疫、微生物等多个亚学科专业实验室;同时配备全自动生化免疫分析流水线、全自动血细胞分析流水线、全自动尿液分析系统、全自动化学发光免疫分析仪、全自动荧光免疫分析仪、全自动凝血分析仪、液相色谱串联质谱分析系统等高端检测仪器设备。
科室严格按照ISO 15189的要求建立、运行质量体系并实现“云平台”管理,一贯秉承“准确、高效、科学、公正”的质量方针,为患者提供优质服务。目前科室已开展检测项目255项,参加国家卫健委临床检验中心室间质评项目155项, “京津冀鲁”和北京市检验结果互认要求项目119项。
检验科始终致力于推动检验医学与临床实践深度融合,不仅为临床诊疗提供客观依据,更以科普服务大众,帮助大众读懂检验报告背后的健康密码。未来,检验科将持续精进技术、优化服务,以专业与温度,成为大家健康路上值得信赖的“幕后守护者”!
咨询电话:68688877-6626
地址:中国中医科学院眼科医院门诊楼二楼西北角检验科








